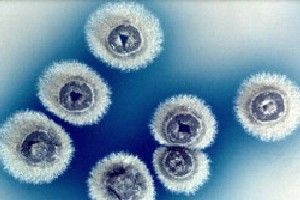
庫爾薩諾夫鏈黴菌NR-7GG1 庫爾薩諾夫鏈黴菌NR-7GG1

基本信息
中文學名:庫爾薩諾夫鏈黴菌NR-7GG1
拉丁學名:StreptomyceskurssanoviiNR-7GG1
參考文獻:J.Antibiotics28:636-647,1975.
形態特徵
孢子絲螺鏇形(只在無機鹽澱粉瓊脂上清楚看到)。孢子卵圓形至柱形,表面光滑。
性狀特徵
高氏合成1號瓊脂、澱粉瓊脂:氣絲淺灰色至暗灰色、灰粉色,豐茂,絨狀。基絲暗橙色。可溶色素黃色、橙色或無。纖維素:氣絲灰色。基絲橙色。甘油天冬素瓊脂(ISP)、無機鹽澱粉瓊脂(ISP):氣絲灰色系列。基絲反面無鑑別色素:灰黃色至黃褐色,對pH不敏感。無可溶色素。酵母精麥芽精瓊脂(ISP):氣絲灰色系列。基絲反面黃褐色加紅色,對pH不敏感。高氏有機2號瓊脂:氣絲淡灰色,相當少或無。基絲菸草褐色。可溶色素菸草褐色。馬鈴薯塊:氣絲大理石粉色至灰色,絨狀。基絲橙色至褐色。無可溶色素。明膠液化快,淺橄欖色素。牛奶不凝固,腖化弱,褐色素。澱粉不水解。纖維素上生長。硝酸鹽還原弱或無。產生類黑色素和H2S。利用D—葡萄糖、L—阿拉伯糖、D—木糖、D—果糖、蔗糖、棉子糖;不利用鼠李糖、肌醇、D—甘露醇。抑制革蘭氏陽性細菌和某些酵母。
形態描述
孢子絲螺鏇形(只在無機鹽澱粉瓊脂上清楚看到)。孢子卵圓形至柱形,表面光滑。
討論
代表菌株:NR-7GG1,分離自日本土樣。
放線菌(二)
| 放線菌因菌落呈放線狀而的得名。它是一個原核生物類群,在自然界中分布很廣,主要以孢子繁殖,其次是斷裂生殖。放線菌在自然界分布廣泛,主要以孢子或菌絲狀態存在於土壤、空氣和水中,尤其是含水量低、有機物豐富、呈中性或微鹼性的土壤中數量最多。放線菌只是形態上的分類,不是生物學分類的一個名詞。有些細菌和真菌都可以劃歸到放線菌。土壤特有的泥腥味,主要是放線菌的代謝產物所致。 |